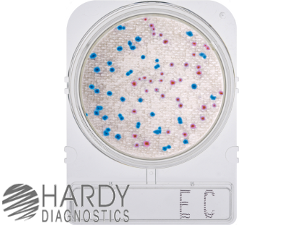

![]() |
Laboratory Investigations in Microbiology |
![]() |
Although we are quite accustomed to safe drinking and swimming water in the United States, many third-world countries do not enjoy a high quality of water. And occasionally, outbreaks of water-borne diseases in the United States, including Listeriosis and E. coli H7:O157, remind us to be ever vigilant against bacterial contaminants in our water supply.
Water-borne pathogens are certainly not limited to bacteria. They include viruses (Hepatitis A, Polio) and protozoa (Giardia, Cryptosporidium). In this exercise, however, we will concern ourselves primarily with detecting bacterial contamination in water samples. Bacteria transmitted through water include Salmonella, Shigella, E. coli, Vibrio cholerae, Listeria, and Yersinia. Many of these pathogens follow the oral-fecal route of transmission and find another host through contaminated drinking water. But even swimming water must meet safety guidelines to avoid illness when exposed to pathogens. Swallowing water while swimming and exposure of open wounds (cuts. scrapes) pose hazards.
To evaluate the level of contamination in water, we do not actually look for pathogenic organisms. Instead, we look for common microbes that are always present with the pathogens, but in much higher numbers. Since most of these pathogens are carried in feces, we look for common fecal coliforms, such as E. coli, Enterobacter, Klebsiella or Citrobacter. These bacteria are known as Indicator Organisms because they indicate the presence of fecal contamination (whether from animals or humans). These indicator organisms are Gram-negative Enterobacteria that all have the ability to ferment lactose, producing both acid and gas in the process. Most water quality tests therefore use media that detect lactose-fermenting bacteria.
The Most Probable Number (MPN) test cultures water samples in tets
tubes of lauryl sulfate (SDS) lactose broth containing a Durham tube. The SDS is
a detergent that makes the medium selective for Gram-negative bacteria. The
Durham tube traps gas bubbles produced by fermentation of the lactose in the
broth. A positive test therefore is when gas bubbles form in a test tube. 15
test tubes are inoculated (5 with 10 ml of water sample, 5 with 1 ml of water
sample, 5 with 0.1 ml of water sample each). Because the odds of having a
positive test in any of the 15 tubes increases with an increase in the number of
coliforms in the water, the number of 10 ml, 1ml, and 0.1 ml sample tubes that
turn out to be positive after 24 hours gives n indication of the level of
coliform contamination in the water. (Imagine a sample of water with 100
coliform bacteria per 100 ml. Taking 10 ml of this sample will almost certainly
always capture at least one (and on average, 10) coliforms, assuring that the
five 10-ml tubes will all show a positive result. However, taking just 0.1 ml
will have only a 10% chance of getting a coliform bacterium, since there is only
1 coliform in each ml. Therefore, one would expect perhaps one of the five 0.1
ml tubes to be positive.). 
The Presence -Absence (P/A) test detects the presence of coliforms in 100 ml of drinking water. The drinking water is mixed with a 3x concentrate of lactose - SDS broth containing a pH indicator (bromthymol blue). If there are any coliforms in the water sample that are capable of fermenting lactose, the acids produced from fermentation will turn the P/A broth yellow, indicating a positive test. A negative test is shown when the color of the medium remains blue/purple. Only coliforms (e.g. E. coli) can ferment lactose. However, manhy pathogenic coliforms s.a. Shigella (SD) do not ferment lactose and thus will not turn the medium yellow. Gram-positive bacteria s.a. SA are inhibited.
The membrane filtration test allows the detection of very small numbers of bacteria in a large volume of water. Using a vacuum, the water sample is drawn through a 0.2 um filter membrane which traps any bacteria on its surface. The filter membrane is then incubated on an agar medium, and resulting colonies are counted.
Chromogenic media can also be used to rapidly distinguish and count coliform or heterotrophic bacteria in water samples. Chromogenic media develop colonies into different colors based on the bacterial species. The ECC medium (Hardy Diagnostics) is selective for Gram-negative bacteria. E. coli forms pink colonies; other, non-E. coli coliforms form turquoise colonies; other Gram-negatives are colorless.
When is water safe to drink or to swim in? Drinking water must be free of fecal coliform contamination. According to the EPA guidelines, drinking water should contain <1 coliform and <1 bacterium per 100 ml. Therefore, even 1 coliform/100 ml makes the water unsafe. For this reason, a simple presence/absence test is sufficient. For the testing of public water systems, a maximum of 1 positive test/month (or 5% of all samples/month if >40 samples taken) is allowed.
Recreational (swimming) water can have more bacteria - indeed, it is virtually impossible to have a natural habitat that is free of coliforms (with the exception of unusual habitats such as the Dead Sea). US Public Health standards for safe swimming water range ~ 100 - 200 coliforms per 100 ml of water. The EPA limit for coliforms in fresh water is 126/100 ml (average level) or 235/100 ml in a single sample. The level for Enterococci, another good indicator of fecal contamination, is 33/100 ml (average) or 98/100 ml in a single sample.
This test is intended for environmental samples (rivers, lakes, streams, ponds,..)
Presumptive test
Confirmed test
Completed test
1. Inoculate your EMB agar plate with a loopful of a lactose broth (presumptive test) that has gas production and growth (positive test).
2. Label and incubate
Confirmed test
Completed test
1. Examine the growth on your EMB plate. Describe colony color.
2. Gram-stain a colony from each streak. Record your data
This test is for detecting coliform bacteria in drinking water
© 2003 - 2018 José de Ondarza, Ph.D.